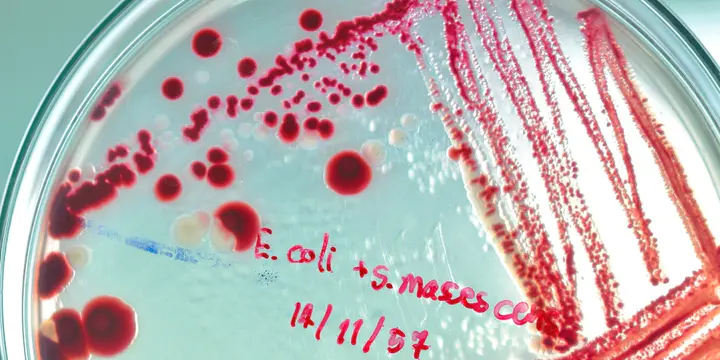

Bactérie E.coli : les autorités sonnent l’alarme après le décès de deux enfants
Depuis le début de l’année, plusieurs dizaines d’enfants de 1 à 15 ans ont été contaminés par la bactérie Escherichia coli. Santé publique France appelle les familles à respecter plusieurs gestes de prévention.
Par La rédaction d'Allo Docteurs
Mis à jour le
Une recrudescence inquiétante. Un deuxième enfant est mort des suites d’une contamination à la bactérie E.coli, depuis le début de l’année. Dans un communiqué publié ce samedi 12 mars, l’agence Santé publique France insiste sur "la prévention des risques alimentaires" après une multiplication des contaminations graves en France.
Au total, 26 cas de syndrome hémolytique et urémique (SHU) "liés à des bactéries E.coli présentant des caractéristiques similaires ont été identifiés" chez des enfants de 1 à 15 ans. "22 cas supplémentaires sont en cours d'investigation", a ajouté l'agence.
A lire aussi : L'épidémie de grippe repart à la hausse en France
Prévention des jeunes et des personnes âgées
Les autorités sanitaires "poursuivent les investigations sur l'ensemble des cas de SHU pédiatriques signalés depuis le 1er janvier 2022 sur le territoire national afin d'identifier une éventuelle source de contamination commune et de mettre en place les mesures appropriées (par exemple retrait-rappels de produits incriminés)", indique le communiqué.
A ce stade, “l'investigation épidémiologique n'a pas permis d'incriminer une source de contamination particulière". C'est pourquoi "les autorités sanitaires renouvellent les recommandations générales de prévention des risques alimentaires, notamment chez les enfants de moins de 16 ans" et les personnes âgées.
E.coli : les bons gestes
Le lavage des mains doit être systématique avant la préparation des repas, rappelle Santé publique France. Les viandes, notamment la viande hachée de bœuf, doivent être bien cuites à cœur. Le lait cru, les fromages à base de lait cru et les produits laitiers fabriqués à partir de lait cru ne doivent, eux, pas être consommés par les enfants de moins de 5 ans.
Fromage au lait cru : quels contrôles dans la production ?
Le Magazine de la Santé - France 5
Les recommandations concernent aussi les préparations à base de farine (pizza/pâte à cookies/gâteau/à tarte...) qui ne doivent pas être consommées crues ou peu cuites. Les légumes, salades, fruits, herbes doivent être soigneusement lavés avant consommation, tout comme les ustensiles de cuisine (surtout lorsqu'ils ont été en contact préalablement avec des aliments crus) et le plan de travail.
Par ailleurs, les enfants ne doivent pas boire d'eau non traitée (eau de puits, torrent, etc.). Il faut aussi éviter le contact des très jeunes enfants (moins de 5 ans) avec les vaches, veaux, moutons, chèvres, daims, etc. En cas de contact avec ces animaux, le lavage des mains doit être systématique, rappelle Santé publique France.










